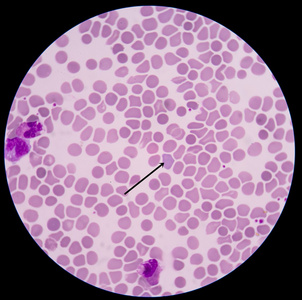
红细胞高渗图片

影红细胞图片

高渗尿中可因脱水皱缩体积减小;低渗尿中可因吸水胀大形成"影红细胞"
图片尺寸650x488
尿沉渣涂片未染色(普通光镜)400 × 影红细胞 2018303 箭头所指 "
图片尺寸395x303
红血细胞显微镜在医学背景概念下
图片尺寸700x688
central retinal artery and vein occlusion
图片尺寸1800x1421
正常红细胞
图片尺寸1200x919
这些红细胞异常,您都掌握了吗?
图片尺寸900x675
红细胞高渗图片
图片尺寸302x300
血液红细胞图片
图片尺寸317x300
新生儿外周血嗜多色性红细胞易见,成熟红细胞大小不一,机测mcv不够准
图片尺寸1200x1600
长"核"的红细胞——带您认识"有核红细胞"
图片尺寸338x219
身体显微镜下红细胞红细胞特写的三维插图科学医学背景概念
图片尺寸700x467
急诊尿液多形红细胞
图片尺寸2976x3968
红细胞检查没有均匀分布和再生成医生说脾脏有黑色团块本来应该是均匀
图片尺寸540x800
红细胞
图片尺寸1200x900
466.请识别箭头所指细胞(血片10x100倍,瑞吉染色)
图片尺寸1353x1069
正常红细胞(图片来源网络)
图片尺寸600x600
1《细胞膜―系统的边界(新人教版必修1) 人部分红细胞已涨破的光镜
图片尺寸1080x810
一例隐藏于血小板计数"正常"背后的ttp|红细胞|溶血性贫血|血细胞|ttp
图片尺寸477x483
网织红细胞图片
图片尺寸317x300
血细胞可分为红细胞,白细胞和血小板.
图片尺寸5760x3162